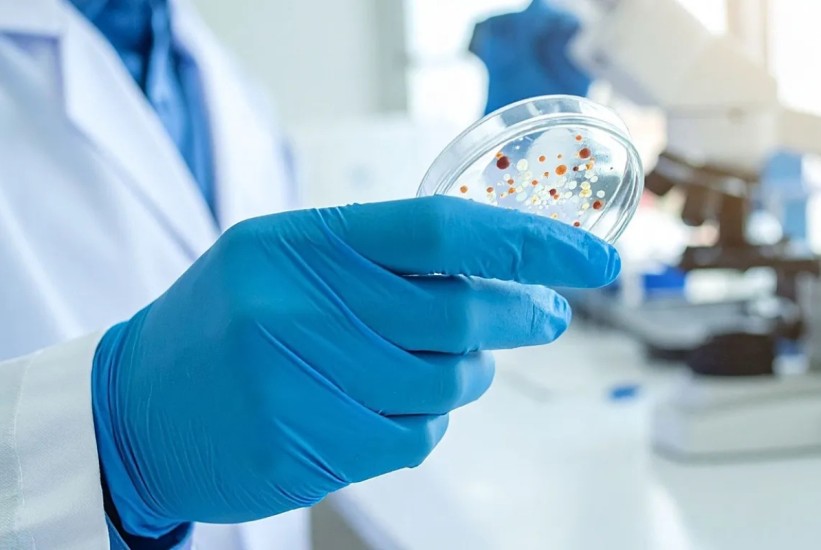
Može li vještačka inteligencija pomoći u borbi protiv superbakterija?

Može li vještačka inteligencija pomoći u borbi protiv superbakterija?
Britanski naučnici uskoro će početi koristiti vještačku inteligenciju (AI) u borbi protiv rastuće prijetnje infekcija koje više ne reagiraju na postojeće terapije. Riječ je o trogodišnjem projektu čiji je cilj razviti nove alate i pristupe u borbi protiv patogena otpornih na lijekove.
Antimikrobna rezistencija – globalna prijetnja u porastu
Antimikrobna rezistencija (AMR) nastaje kada bakterije, virusi ili gljivice evoluiraju do tačke u kojoj postojeći lijekovi više ne djeluju. Prekomjerna upotreba antibiotika u medicini i poljoprivredi dodatno ubrzava taj proces, stvarajući tzv. superbakterije.
Prema globalnim podacima, otprilike jedna od šest laboratorijski potvrđenih bakterijskih infekcija danas je otporna na antibiotike, a procjene pokazuju da bi AMR mogao direktno uzrokovati 39 miliona smrti do 2050. godine.
Velika investicija i saradnja stručnjaka
Novi istraživački program finansira se sa 45 miliona funti (oko 51 milion eura) koje je osigurala farmaceutska kompanija GSK. Projekat vodi The Fleming Initiative, britanska grupa koja okuplja naučnike, kreatore politika i zdravstvenu industriju.
U njemu će učestvovati oko 50 istraživača, a rad počinje početkom sljedeće godine.
„Antimikrobna rezistencija jedan je od najvećih izazova s kojima se suočavamo u NHS-u i širom svijeta“, rekao je Tim Orchard, izvršni direktor Imperial College Healthcare NHS Trusta, jedne od vodećih institucija u projektu.
Ciljano djelovanje protiv najopasnijih patogena
Istraživanja će biti fokusirana na nekoliko mikroorganizama koje je Svjetska zdravstvena organizacija označila kao prioritete, uključujući:
gljivicu Aspergillus,
Gram-negativne bakterije poput Escherichia coli i Klebsiella pneumoniae,
Staphylococcus aureus, uključujući MRSA.
AI u službi razvoja novih antibiotika i vakcina
U okviru projekta planirana su dva ključna pravca istraživanja:
Razvoj AI modela za dizajn novih antibiotika
Naučnici će koristiti napredne algoritme kako bi osmislili i testirali nove lijekove za teške, višestruko otporne Gram-negativne infekcije. GSK je najavio da će svi prikupljeni podaci i AI modeli biti dostupni globalnoj naučnoj zajednici.
Bolje razumijevanje imunološkog odgovora na S. aureus
Druga grupa istraživača koristit će AI kako bi dublje analizirala kako ljudski imuni sistem reaguje na ovu bakteriju—što bi moglo pomoći u razvoju prve efikasne vakcine protiv ovih infekcija.
„Hitno trebamo nove terapije i intervencije za borbu protiv infekcija otpornih na lijekove — a to možemo postići samo ako udružimo stručnost“, naglasio je Orchard.










